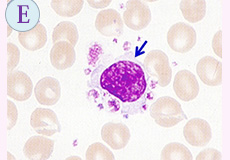

第98回 「マンスリー形態マガジン」 2019年6月号
『春雨に濡れた有田陶器市』
去る4月29日から7日間、第116回有田陶器市が新緑の薫る佐賀県有田町で開催されました。私は、今年も開催日に知人の車に便乗し、早朝から意気込んで陶器市に向かいました。現地集合の知人たちと合流し、陶器市を散策していましたが、あいにくの小雨模様で午後からは本降りとなってしまい、やむなく散会となりました。
ここ数年は天候には恵まれていましたので残念でしたが、道中での気ままな買い物や他愛もない会話を楽しみました。陶器市では、その後天候にも恵まれ、会期中の人出が、昨年よりも2万人多い約126万人だったそうです。陶器市では、最終日になると、“100円ですよ‥どうですか”と客引きのかけ声や沿道の賑いにはいつも心が和まされます。また、気に入った陶器を如何に安く仕入れるかが腕のみせどころです。
有田陶器市の始まりを調べてますと、その昔、有田は弘法大師開山の黒髪山に訪れるお遍路さんたちの通り道であり、窯元や商家の人たちは、お遍路さんのため半端物や等外品をザルや箱に入れて売ったそうです。明治29年、深川栄左衛門氏と田代呈一氏の主催で陶磁器品評会が開催され、その後、この品評会と同時に開催されるようになった蔵ざらえ大売出しが現在の有田陶器市の始まりとされています。
毎年気に入った陶器を少しですが購入していますが、我が家の食卓に並ぶことでささやかな食事にも
彩りを添えてくれてます。同じ時期に、江戸時代から続く大衆向けの波佐見陶器市(長崎県波佐見町)も開催されており、近年とても人気があります。皆さんも是非、有田や波佐見の陶器市にお越しになってみませんか。

形態マガジン号キャプテン 阿南 建一 
今回のねらい
今回は、細胞同定と症例検討を提示しました。
細胞編は、末梢血液像に遭遇する未確認な細胞を提示しました。
これらは採血や疾患、はたまた薬剤によって起る事例です。
症例編は、共に貧血が先行する疾患群ですが、経過後、改善されました。骨髄像のMG染色から臨床診断を試みて下さい。
問題
末梢血液像にみられた未確認物体ですが同定してみて下さい。
光顕的所見から臨床診断を考えて下さい。
【症例】
(A)60歳代の男性、(B)4~6歳の女児
これらの細胞像は、共に一つの疾患群に含まれるものですが、貧血が指摘され、その精査のために骨髄検査が施行されました。骨髄のMG染色を提示しますので形態学的所見を考えて下さい。そして、発症の原因を模索し、該当する疾患を考えてみましょう。尚、共に経過後、貧血は改善されました。
解答・解説
問題 1
末梢血液像にみられた未確認物体ですが同定してみて下さい。
【解説】
BM-MG.1000

-
末梢血で遭遇する未確認細胞を提示しました。なかにはアーチファクトのものもあり、これらについては自動血算器で血球数の偽低値や偽高値を示すので認識し回避策を講じる必要があります。
【正答】
A.クリオグロブリン、B.γ-グロブリン?、C-1.リンパ球、2.血小板、D.フイブリン糸、E. 血小板衛星現象、F.巨大血小板(奇形)
【解説】
A.6時方向に正常な血小板3個を認めますが、その上部に血小板大の辺縁不明瞭な淡染性の球体を多数認めます。一見、血小板凝集像を思わせますが顆粒が全く認めないことから否定されます。本例はクリオグロブリン血症であり、4℃前後の冷却によって出現した異常タンパク(M蛋白)と思われます。IgMが大量に増加するマクログロブリン血症でよく遭遇します。また、この場合は、血算値は血小板数が偽高値を示しますので37℃で加温し、再測定する必要があります。
B.本例は、γ-グロブリン大量投与後に末梢血塗抹標本に雲状の物質としてみられたものです。原因は不明ですがこれらではないかと思われます。染色性はやや好酸性から好塩基性を呈し、このように大きい場合には血小板数に与える影響はないようです。
C.全体像から4個の細胞は楕円状を呈しています。この塗抹法はスピナー標本ですが、採血後時間を経過したものほど楕円状の形態をとるようです。これらの形状は類似していますが、1.は核の染まりからリンパ球、2.は顆粒の染まりから巨大血小板(中央付近の血小板より大きい)と思われます。免疫性血小板減少症(ITP)の症例です。
D.白血球の周囲を血小板が付着した血小板衛星現象です。通常なら好中球を付着することが多いのですが、このように単球にもみられます。この細胞の核はリンパ球を思わせますが、細胞質の広さと辺縁の不整から単球と思われます。IgG型の凝集素が関与しているといわれ、血小板数は偽低値を呈します。
E.約40µm大の巨大血小板です。数ヵ所節くれ立った部分がみられ、通常、この部分から分離されて血小板になるものと思われますが、そのまま連なった状態のようです。本例はMay-Hegglin異常症でみられた奇形の巨大血小板です。
問題 2
【解説】


-
提示例は(A)高齢の女性、(B)幼児の女児です。共に赤血球数とヘモグロビン量が減少し、骨髄では成熟傾向を呈する顆粒球系が優位で赤芽球系の減少が目立ちました。A、B共に後天性赤芽球癆(pure red cell aplasia:PRCA)と診断されたものです。
【症例.A】
Hb.6.5g/dL, 網赤血球 0%。正形成の骨髄は、顆粒球系が優位で赤芽球の抑制が顕著のようです。本例の診断には直接関係ありませんが、中央部に二核の好中球の形態異常を認め(赤印)、他に輪状核好中球もみられます(青印)が、これは核の一部が重なったものと思われます。臨床的に胸腺腫を認め、胸腺腫と貧血から赤芽球癆が考えられ、胸腺摘出術が施行されました。胸摘後、貧血は改善され(Hb12.8g/dL, 網赤血球 2.2%)、後天性赤芽球癆(慢性型)と診断されました。発症機序については不明とされますが、T細胞機能異常による造血調節機能不全が考えられています(Mamiya S,et al.1997)。尚、PRCAに胸腺腫を合併する頻度は約50%とされます(正岡昭ほか.1991)。
【症例.B】
本例は遺伝性球状赤血球症で、初診時 Hb9.0g/dL, 網赤血球11.2%でした。経過中に貧血(Hb7.3g/dL)と網赤血球の減少(0.2%)を呈し、骨髄検査が施行されました。正形成の骨髄は、顆粒球系が優位で赤芽球系のみの減少が顕著でしたが、残存する前赤芽球は巨大化を起しています。臨床的に伝染性紅斑を認めたこととヒトパルボウイルスB19(HPVB19)-IgM抗体が証明されたことから、ウイルス感染による後天性赤芽球癆(急性型)と診断されました。ウイルスの浸入を受けた前赤芽球は巨大化(感染赤芽球?)し、顕著な異型性を示すのが特徴で、この所見は上記の慢性型(A)とは異なる形態像です。本例では、ウイルスに対する中和抗体が産生され、ウイルスが排除されると共に赤芽球は一過性の過形成像を呈し、網赤血球も著増します。このような溶血性貧血では、ウイルス感染が合併することが多いとされます。
【総括】
PRCAは赤芽球前駆細胞の障害によって発生し、骨髄の赤芽球系の単独減少は原則として5%以下、末梢血の網赤血球は1%未満とされ、また末梢血にLGLの増加を認めることがあります(PRCAの診断基準と診療の参照ガイド作成のためのワーキンググループ.2005)。先天性にはDiamond-Blackfan貧血があります。
これから先のページでは、医療関係者の方々を対象に医療機器・体外診断薬等の製品に関する情報を提供しております。当社製品を適正に使用していただくことを目的としており、一部の情報では専門的な用語を使用しております。
一般の方への情報提供を目的としたものではありませんので、ご了承ください。
医療関係者の方は、次のページへお進みください。
(お手数ですが、「進む」ボタンのクリックをお願いします)

